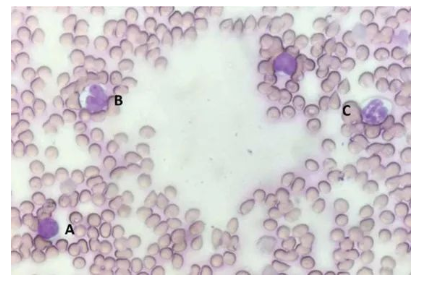

血液學(xué)檢查是動(dòng)物疾病狀態(tài)評(píng)估、術(shù)前檢查和常規(guī)體檢中必不可少的內(nèi)容。評(píng)估血常規(guī)檢測報(bào)告的可靠性并解讀其結(jié)果是獸醫(yī)朋友們的工作日常。本文就血液學(xué)檢查的一些要點(diǎn)進(jìn)行分析探討。
采血是進(jìn)行血常規(guī)檢查的第一步,本公眾號(hào)曾經(jīng)發(fā)表《獸醫(yī)隨筆:實(shí)驗(yàn)動(dòng)物采血指南》一文,介紹采血量和采血點(diǎn)的一般指導(dǎo)意見。
進(jìn)行血液學(xué)分析時(shí)通常建議用EDTA抗凝管采集樣本,但采集時(shí)應(yīng)該注意抗凝劑和血液的比例。樣本質(zhì)量會(huì)顯著影響檢測結(jié)果,常見的樣本質(zhì)量問題有:
抗凝效果不佳導(dǎo)致出現(xiàn)血凝塊,會(huì)使血小板(PLT),白細(xì)胞(WBC),紅細(xì)胞(RBC),紅細(xì)胞壓積(HCT)假性降低;
溶血會(huì)使RBC、HCT假性降低的同時(shí)平均紅細(xì)胞血紅蛋白濃度(MCHC)、平均紅細(xì)胞血紅蛋白(MCH)假性升高;
乳糜血會(huì)使血紅蛋白(Hb)、MCHC、MCH假性升高;
樣本不新鮮會(huì)使紅細(xì)胞形態(tài)發(fā)生改變導(dǎo)致MCV和HCT假性升高,MCHC假性降低,同時(shí)白細(xì)胞形態(tài)也會(huì)發(fā)生改變。
紅細(xì)胞、白細(xì)胞和血小板是血常規(guī)報(bào)告中需要解讀的三個(gè)方面。
紅細(xì)胞
相比于人及其他哺乳類動(dòng)物,嚙齒類動(dòng)物的紅細(xì)胞自有其特征。倉鼠的RBC約6.0微米,豚鼠的約7.8微米。大鼠出生時(shí)紅細(xì)胞較大(10.03 μm),但在出生后30天內(nèi)變到小于6μm。小鼠RBC大小約4-7μm,隨年齡增長而增加。多色性是嚙齒類動(dòng)物血象的一個(gè)常見特征。在豚鼠血涂片上還可見紅細(xì)胞疊連。特定疾病模型小鼠中,如β地中海貧血模型小鼠RBC可觀察到異常形態(tài),例如靶形紅細(xì)胞、棘形狀紅細(xì)胞、淚滴狀紅細(xì)胞、破碎狀紅細(xì)胞、有核紅細(xì)胞等。

(圖片來源:https://www.researchgate.net/publication/233535082)
和大多數(shù)哺乳動(dòng)物(包括人)不同的是,新生嚙齒類動(dòng)物(小鼠、大鼠、豚鼠、沙鼠)的血紅蛋白和血細(xì)胞比容值低于成年動(dòng)物;新出生大鼠有16%的網(wǎng)織紅細(xì)胞,成年后則減少至2.5%;據(jù)報(bào)道,大鼠、沙鼠的RBC計(jì)數(shù)存在性別差異,雌性的計(jì)數(shù)通常比雄性高。不同品系的小鼠和大鼠,血紅蛋白值也會(huì)有很大的差異。
樣本采集部位或麻醉的影響會(huì)導(dǎo)致血常規(guī)數(shù)據(jù)的變化。例如,從大鼠尾部采集的樣本中的血紅蛋白和紅細(xì)胞比容比從腹主動(dòng)脈或心臟中采集的樣本中要高。豚鼠中已經(jīng)證實(shí)RBC值可能由于麻醉期間發(fā)生脾內(nèi)紅細(xì)胞扣留而降低。
影響RBC參數(shù)的非致病性條件還包括妊娠、季節(jié)變化等。在大鼠中,紅細(xì)胞比容在妊娠期間減少。在倉鼠中,RBC計(jì)數(shù)、血紅蛋白濃度和紅細(xì)胞比容在冬眠期間升高,這是因?yàn)樵诙咂陂g,倉鼠基礎(chǔ)代謝率降低,RBC壽命延長了。
紅細(xì)胞和貧血
紅細(xì)胞指標(biāo)重點(diǎn)關(guān)注RBC、HCT和Hb,它們的變化可以提示動(dòng)物貧血或紅細(xì)胞增多。
嚙齒類動(dòng)物中并沒有原發(fā)性的紅細(xì)胞增多癥,但可能見于輕度脫水的動(dòng)物。貧血?jiǎng)t較為常見。初步判斷為貧血后,還需要關(guān)注平均紅細(xì)胞體積(MCV),MCH和MCHC,可用于輔助判斷貧血類型,這三項(xiàng)都偏低常見于缺鐵性貧血,而高于正常范圍多見于葉酸或維生素B12缺乏引起的貧血。網(wǎng)織紅細(xì)胞是尚未完全成熟的紅細(xì)胞,是反映骨髓造血功能的重要指標(biāo)。當(dāng)其升高時(shí),提示骨髓造血功能旺盛,可能有溶血性貧血、缺鐵性貧血等;而當(dāng)其降低時(shí),可能有再生障礙性貧血、急性白血病等。
儀器分析的血常規(guī)化驗(yàn)單只能給出各種細(xì)胞的數(shù)量,但并不能給出細(xì)胞形態(tài)的異常描述。因此為了更準(zhǔn)確分析血液學(xué)檢查結(jié)果還建議對(duì)血樣涂片進(jìn)行形態(tài)學(xué)檢查。
RBC形態(tài)學(xué)可區(qū)分貧血的原因:出血、溶血、缺鐵、非再生性貧血、骨髓疾病或淋巴細(xì)胞增生性疾病(白血病)等。
如果診斷為溶血性貧血,則需要在血涂片中尋找血液寄生蟲的證據(jù),如球狀附紅細(xì)胞體和鼠血巴爾通體可能導(dǎo)致小鼠或大鼠貧血。如果出現(xiàn)小紅細(xì)胞增多癥、血色素減少、總蛋白低、血小板增多和網(wǎng)織紅細(xì)胞計(jì)數(shù)升高則提示有慢性失血,建議檢查體表寄生蟲,在虱子嚴(yán)重感染的豚鼠和大鼠中可見這種現(xiàn)象。
白細(xì)胞
白細(xì)胞是機(jī)體抵御感染、調(diào)控炎癥、免疫和造血的關(guān)鍵。
嚙齒類動(dòng)物的白細(xì)胞形態(tài)和其他哺乳動(dòng)物相似,但又有一定區(qū)別,嚙齒類動(dòng)物的粒細(xì)胞被稱為嗜異性或假嗜酸性粒細(xì)胞,因?yàn)樗屑t色顆粒,與嗜酸性粒細(xì)胞相似。豚鼠有獨(dú)特的Foa-Kurloff細(xì)胞(一種T淋巴細(xì)胞),含有一個(gè)大的細(xì)胞質(zhì)包涵體。嚙齒類動(dòng)物的白細(xì)胞類型與其他哺乳動(dòng)物相似,但淋巴細(xì)胞數(shù)量遠(yuǎn)超過粒細(xì)胞:淋巴細(xì)胞約占86%,中性粒細(xì)胞約占10% ~ 25%,單核細(xì)胞約占6%,嗜酸性粒細(xì)胞約占1% ~ 4%,嗜堿性粒細(xì)胞很少。WBC計(jì)數(shù)每天都會(huì)發(fā)生波動(dòng),因此采集樣本的位置和時(shí)間不同,結(jié)果也可能不同。中性粒細(xì)胞計(jì)數(shù)隨著大鼠年齡的增長而增加,淋巴細(xì)胞計(jì)數(shù)隨著年齡的增長而減少。
白細(xì)胞:淋巴細(xì)胞
淋巴細(xì)胞增多
淋巴細(xì)胞分為T淋巴細(xì)胞和B淋巴細(xì)胞,大多在外周淋巴組織中生成并在血液和淋巴組織中循環(huán)。淋巴細(xì)胞的增多大多為生理性的。反應(yīng)性淋巴細(xì)胞增多的原因包括注射疫苗后的短暫反應(yīng)、長期免疫刺激、甲狀腺功能亢進(jìn)等;腎上腺皮質(zhì)功能減退也會(huì)導(dǎo)致淋巴細(xì)胞增多,并常伴隨低血糖、電解質(zhì)異常,出現(xiàn)高鉀低鈉和高鈣血癥;淋巴瘤、胸腺瘤可見淋巴細(xì)胞異常升高,淋巴細(xì)胞性白血病則在淋巴細(xì)胞異常升高的同時(shí)伴有其他細(xì)胞系的減少。
淋巴細(xì)胞減少
淋巴細(xì)胞減少最常見的原因是內(nèi)外源性皮質(zhì)類固醇激素增多,導(dǎo)致其從血液循環(huán)中轉(zhuǎn)移到淋巴組織中。在急性炎癥反應(yīng)、病毒感染以及發(fā)生內(nèi)毒素血癥和敗血癥時(shí),也可見淋巴細(xì)胞減少。免疫缺陷病毒感染、免疫抑制藥物的使用也會(huì)讓淋巴細(xì)胞生成減少。淋巴回流受阻或丟失也會(huì)讓其計(jì)數(shù)減少。
(A)淋巴細(xì)胞,特征是有深紫色圓形核;(B)單核細(xì)胞,特征是有腎形細(xì)胞核;(C)中性粒細(xì)胞,特征為有紫色多小葉細(xì)胞核。(圖片來源:Bjorner & Zhu, 2019)‘’
白細(xì)胞:中性粒細(xì)胞
中性粒細(xì)胞增多
與其他哺乳動(dòng)物一樣,急性炎癥反應(yīng)的特征是中性粒細(xì)胞增多并有核左移。但并不是出現(xiàn)中性粒細(xì)胞增多就意味著急性炎癥反應(yīng),動(dòng)物經(jīng)歷劇烈運(yùn)動(dòng)、驚嚇傷心等強(qiáng)烈情緒后也可出現(xiàn)生理性中性粒細(xì)胞增多,但不會(huì)出現(xiàn)核左移。
應(yīng)激或皮質(zhì)類固醇也可導(dǎo)致動(dòng)物出現(xiàn)中性粒細(xì)胞數(shù)量增加,無左移。
此外慢性粒細(xì)胞性白血病、中性粒細(xì)胞功能障礙也可使中性粒細(xì)胞數(shù)量增加,同時(shí)出現(xiàn)核左移、多組織髓外生成粒細(xì)胞、血小板減少等異常。
正常情況下,外周血液中性粒細(xì)胞以分葉核為主,胞核常分為2~5葉,桿狀核較少。中性桿狀核粒細(xì)胞增多或(和)出現(xiàn)晚幼粒細(xì)胞、中幼粒細(xì)胞,甚至原始/早幼粒細(xì)胞的現(xiàn)象,稱為核左移。
中性粒細(xì)胞減少
中性粒細(xì)胞減少也非常常見,其中臨床常見的因素為嚴(yán)重的細(xì)菌感染,例如肺炎、敗血癥、腹膜炎等,常會(huì)伴隨核左移和中毒性變化。骨髓疾病、藥物毒性、病毒感染和腫瘤等也可造成中性粒細(xì)胞減少,同時(shí)可能會(huì)伴有紅細(xì)胞和血小板的減少。
白細(xì)胞:嗜酸性粒細(xì)胞
嗜酸性粒細(xì)胞主要聚集在皮膚、消化道和呼吸道黏膜等疏松結(jié)締組織中,它的增多常見于寄生蟲感染的動(dòng)物和發(fā)生I型超敏反應(yīng)的動(dòng)物。也由于其分布特點(diǎn),大多血液寄生蟲不會(huì)引起嗜酸性粒細(xì)胞增多。此外,還有一些臨床原因可導(dǎo)致嗜酸性粒細(xì)胞增多,比如嗜酸性粒細(xì)胞性腸炎、嗜酸性肌炎等炎癥反應(yīng);某些能促進(jìn)嗜酸性粒細(xì)胞生成和釋放的腫瘤(淋巴瘤、鱗狀細(xì)胞癌等);腎上腺皮質(zhì)機(jī)能減退等。
白細(xì)胞:嗜堿性粒細(xì)胞
嗜堿性粒細(xì)胞參與遲發(fā)性過敏和寄生蟲免疫反應(yīng),因此嗜堿性粒細(xì)胞增多癥常和嗜酸性粒細(xì)胞增多癥同時(shí)發(fā)生。此外還可見于高脂血癥、嗜堿性粒細(xì)胞性白血病和骨髓增生性疾病。
白細(xì)胞:單核細(xì)胞
單核細(xì)胞等主要功能是吞噬作用、調(diào)節(jié)炎癥反應(yīng)、參與抗原提呈、參與鐵的調(diào)節(jié)。因此當(dāng)機(jī)體出現(xiàn)急性或慢性炎癥、組織壞死時(shí),都會(huì)導(dǎo)致單核細(xì)胞增多。中性粒細(xì)胞減少時(shí)也會(huì)出現(xiàn)單核細(xì)胞代償性增加。其他不常見的原因還包括應(yīng)激或類固醇、單核細(xì)胞白血病等。嚙齒類動(dòng)物中,多達(dá)25%的F344大鼠會(huì)發(fā)生單核細(xì)胞性白血病。發(fā)病動(dòng)物外周血中,可見非典型性單核細(xì)胞,白細(xì)胞計(jì)數(shù)極度增高和溶血性貧血。
血小板
血小板為骨髓巨核細(xì)胞胞漿裂解脫落的小塊胞質(zhì),其主要作用是凝血和止血,修補(bǔ)破損血管。嚙齒類動(dòng)物的血小板數(shù)量和凝血過程與其他哺乳動(dòng)物相似。在小鼠、大鼠或豚鼠中,未觀察到血小板計(jì)數(shù)的性別或品系差異。大鼠的血小板會(huì)聚集,計(jì)數(shù)往往不可靠。
血小板減少
血小板減少癥發(fā)生時(shí),動(dòng)物可出現(xiàn)瘀斑、瘀點(diǎn)、黏膜出血、止血困難等。但血液分析儀判讀為血小板減少時(shí),應(yīng)做血涂片確認(rèn)是否發(fā)生凝集,因?yàn)檠“遄鲅翰杉?、運(yùn)輸、儲(chǔ)存過程中會(huì)活化并凝集進(jìn)而影響機(jī)器讀取數(shù)據(jù)。通過無創(chuàng)性靜脈穿刺采血、使用檸檬酸鹽抗凝劑、減少采樣后儲(chǔ)存時(shí)間、避免低溫等措施可以減少這種影響。
通常血小板減少是一過性的,跟多種系統(tǒng)性疾病都有關(guān)聯(lián),隨著疾病的康復(fù),血小板計(jì)數(shù)也會(huì)恢復(fù)正常。持續(xù)性的或進(jìn)行性的血小板減少癥表明血小板生成或消耗持續(xù)失衡。例如血小板減少伴隨白細(xì)胞減少和(或)貧血通常提示骨髓疾病引起的造血功能障礙;免疫介導(dǎo)的破壞等。
血小板增多
血小板計(jì)數(shù)增多可能由原發(fā)性血小板增多癥、骨髓增殖性疾病和繼發(fā)性血小板增多癥引起。